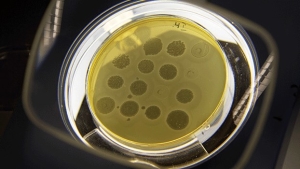

Den Europæiske Fødevaresikkerhedsautoritet, EFSA, og det Europæiske Center for Sygdomsforebyggelse og -kontrol, ECDC, har offentliggjort den årlige zoonoserapport for 2018. Rapporten indeholder tal for, hvor mange europæere er blevet syge af en række forskellige zoonoser, samt i hvilke dyrearter og fødevarer de sygdomsfremkaldende mikroorganismer er fundet.
Zoonoser er sygdomme, som kan smitte fra dyr og fødevarer til mennesker.
Campylobacter stadig skyld i flest sygdomstilfælde
Af 5.146 registrerede fødevarebårne sygdomsudbrud i Europa i 2018 var salmonellabakterier skyld i næsten en tredjedel af udbruddene. Den hyppigste kilde til udbruddene var æg. Et udbrud er, når mindst to personer bliver syge efter at have spist den samme forurenede føde- eller drikkevare.
Campylobacterbakterier er dog stadig skyld i langt de fleste registrerede fødevarebårne sygdomstilfælde i Europa. Faktisk var bakterien i 2018 årsagen til 246.571 registrerede tilfælde, hvilket svarer til 70%.
Salmonellabakterier er med 91.857 sygdomstilfælde den anden-hyppigste årsag til sygdom, mens STEC-bakterier med 8.161 sygdomstilfælde ligger på tredjepladsen.
Vestnilfeber var årets højdespringer
Tilfælde af den myggebårne sygdom vestnilfeber er syvdoblet fra 2017 til 2018, fra 212 til 1.605 registrerede tilfælde. Således er flere humane sygdomstilfælde registreret i 2018 end det samlede antal registrerede tilfælde fra 2011 til 2017. Sygdommen er oftest registreret i Italien, Grækenland og Rumænien.
Rapporten angiver ingen årsager til den store stigning men konstaterer blot, at virussen er i omløb i mange EU-medlemslande, hvor den er årsag til sygdom i mennesker, heste og fugle.
Listeriainfektioner har ofte alvorlige konsekvenser
Af de sygdomme, rapporten dækker, har listeriainfektioner de mest alvorlige konsekvenser. Af de 2.549 registrerede sygdomstilfælde har mindst 40% af patienterne været indlagt i forbindelse med sygdommen og mindst 15% af patienterne er døde.

